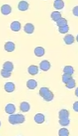

Lesson 5: Cold Lemonade on a Hot Day! V4
Ms. Abdul-Akbar and Mr. Francisque were visiting their friend, Ms. Arlauskas. They were in Ms. Arlauskas's backyard, enjoying some ice-cold lemonade. They noticed that there were droplets on the outside of the pitcher of lemonade.